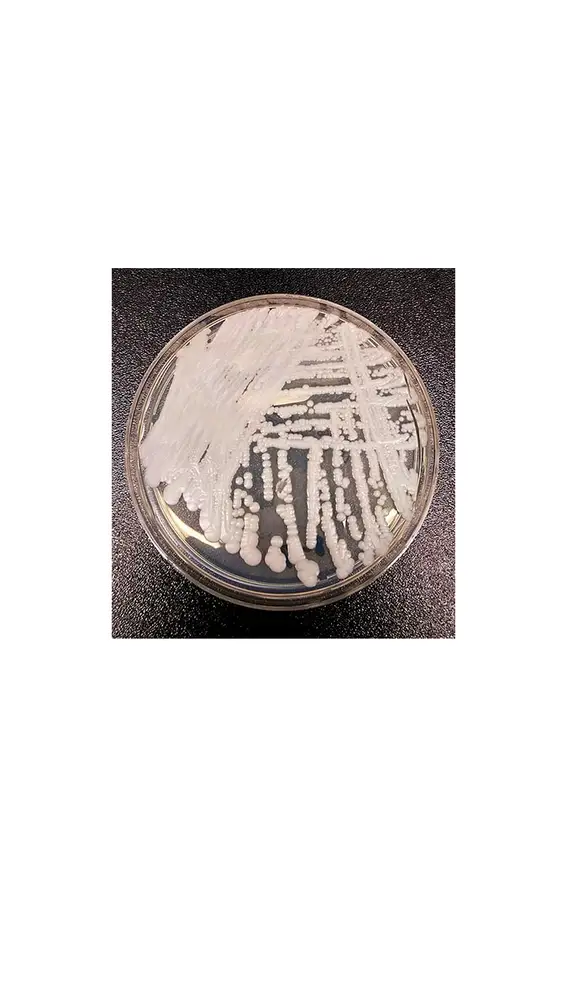
Hongo cándida auris Hongo cándida auris

Alertan sobre un hongo mortal que podría convertirse en la primera enfermedad provocada por el cambio climático
Un reciente estudio ha revelado que existe un hongo, el cándida auris, que podría suponer la primera enfermedad derivada del cambio climático.

El hongo 'cándida auris' se ha convertido en un patógeno humano resistente a los fármacos antifúngicos. Un nuevo estudio realizado por la Sociedad Americana de Microbiología ha detectado que este hongo puede desarrollar la primera enfermedad provocada por el cambio climático.
El considerable aumento de las temperaturas ambientales en todo el planeta ha provocado que el cambio climático se convierta en una gran amenaza. Que el calor sea tan elevado ha provocado que los hongos se estén adaptando paulatinamente a temperaturas superiores a las de su hábitat. Esto es lo que los hace inmunes a los fármacos antimicóticos (que combaten las infecciones por hongos).
Lo que no se explican los científicos es cómo la 'cándida auris' ha emergido en tres zonas geográficas diferentes a la vez. Por el momento y tal y como explican en TecnoExplora, el hongo ha afectado a personas con el sistema inmunológico débil.
👉 COMPROMISO EUROPA FM
Desde Europa FM reforzamos cada año nuestro compromiso con el medio ambiente, organizando campañas de concienciación dentro del marco #RespiraEuropaFM. Así, hemos vivido el Otoño Ecológico, con el que os animábamos a dejar de lado el coche para optar por medios de transporte más ecológicos y saludables, regalando bicis plegables; la #PrimaveraSinPlásticos, cuyo objetivo era ser conscientes de nuestros hábitos diarios para adoptar otros más sostenibles para el medio ambiente, libres de plásticos "de un solo uso".
Ahora es el momento de poner el foco en los puntos negros medioambientales, con el objetivo de que su visibilización redunde en su erradicación, por eso lanzamos la campaña #AlertaEcoEuropaFM, para que nuestros oyentes puedan denunciar a través de Twitter e Instagram esas zonas de nuestras ciudades, plazas e incluso montes y playas que habitualmente están llenas de residuos como botellas y plásticos. ¡Únete!